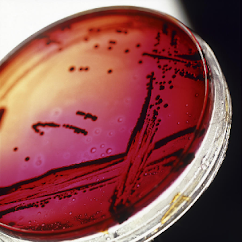

Mitchell Hadley's Blog: It's About TV!, page 77
March 25, 2022
Around the dial

 Xet's start this week with bare-bones e-zine, as Jack's Hitchcock Project introduces us to a new writer: Sarett Rudley who adapted the magazine story "
The Baby Sitter
" into a teleplay of the same name for the series' first season. The story stars two greats, Thelma Ritter and Mary Wickes, but still lacks that certain, what, je ne sais quoi?
Xet's start this week with bare-bones e-zine, as Jack's Hitchcock Project introduces us to a new writer: Sarett Rudley who adapted the magazine story "
The Baby Sitter
" into a teleplay of the same name for the series' first season. The story stars two greats, Thelma Ritter and Mary Wickes, but still lacks that certain, what, je ne sais quoi? Being a writer myself, I tend to attach a certain importance to how well-written a television show is, and my fellow writer David shares that interest in this week's Comfort TV entry, in which he looks at what may be the best written shows in TV history, as selected by the Writers' Guild. How much did they get right? You be the judge. . .
Great news from Jodie at Garroway at Large: the document has gone to the printer! That means we're that much closer to getting the definitive Dave Garroway biography . And yet, as she points out, there still a lot of work to be done. Pretty exciting!
The Broadcasting Archives links to an NPR piece on the end of the Maury Povich show after a 30-year run. That sound you're hearing is champagne corks popping everywhere, although I don't mean that as a personal slam at Maury, who is probably a great guy. It's just that—well, you know my feelings about reality television.
At Silver Scenes a favorite episode from The Avengers: " You Have Just Been Murdered ." It's a terrific story from the Steed and Mrs. Peel era, with a clever, witty script and a great villain in Mr. Needle, played by George Murcell.
Over at Cult TV Blog, John continues the Orphaned Episodes series with a closer look at "A Woman Sobbing," one of the surviving episodes from the 1972 supernatural anthology Dead of Night on BBC. think Gaslight, and you're on the right track.
Next up, Terence at A Shroud of Thoughts reviews the classic Maverick fourth-season episode " Hadley's Hunters ," which includes just about every Western star on a Warner Bros. series. And I'll say one more time, no relation! If you know or have heard of anyone named Hadley, we're not related!
At Drunk TV, Paul undertakes the massive task of looking at Gunsmoke , one of television's most influential shows (of any kind, let alone Westerns), starting with season one (of 20). I really enjoyed reading this piece for a number of reasons.
Finally at Once Upon a Screen, Aurora has a warm, touching tribute to her mother, who passed away last December. Her stories about watching television with mom remind us—and we could use it—that television was always intended to be a communal experience, to be watched and shared with others. That, in large measure, is where it derives its power from, and let's not forget it. TV
Published on March 25, 2022 05:00
March 23, 2022
The Descent into Hell: "The Architects of Fear" (1963)

 The time: the early 1960s.
The time: the early 1960s.The place: a secret conference room in a secret underground laboratory somewhere in the world.
The audience: a dozen of the world’s top scientists.
As we look in, Scientist A is addressing the group:
"And, gentlemen, I’m pleased to announce that, with another week or two of testing, we will have turned science fiction into fact with the production model flying car!"
A hearty round of applause follows.
Scientist B then stands up. "I believe I may have done my learned colleague one better," he begins. Inserting his hand in his pocket he withdraws a small, metallic-looking rectangle slightly bigger than a credit card. "In a matter of months we will introduce a miniature telephone that not only fits in the pocket, but allows the person calling and the person being called to see each other live and in color!"
A confused murmur runs through the room. "Why would anyone want that?" one of the scientists says, as others nod their agreement.
An important-looking man (for they are all men) sitting at the head of the table interrupts the conversation. "Fellow scientists, if I may have your attention! We have something far more important to consider here than flying cars and miniature telephones. It is nothing less than the survival of mankind. Gentlemen, I am talking about world peace."
The room falls silent.
"We stand here today on the precipice of thermonuclear war. Never before have men had the ability to destroy life as we know it with such ease. Our leaders have proven themselves too impetuous, too ideologically rigid, to be trusted with such power. The average citizen is too occupied with his own problems to do anything about it. Therefore, my colleagues, the duty falls to us. It is up to us, and us alone, to save the world from itself."
There are murmurs of agreement all around.
"I have spoken with several of you over the past weeks," the Head Scientist continues, "and I believe we have hit upon the broad outline of an idea. It is our job today to turn that idea into reality, to come up with a plan that will bring all men together as one to ensure peace and harmony for all."
"But how?" Scientist C asks, on behalf of all the men in the room.
"We must concoct a threat that is so grave, so unthinkable, so overpowering in its ability to terrify, that it will unite all humanity against this perceived, common threat."
"Brilliant!" Scientist D shouts. The rest share their agreement, and the men set about discussing what such a threat would look like.
 "Eureka! I’ve got it!" Scientist E exclaims. "What about a deadly virus that infects people indiscriminately and has no known cure. It moves through the air, and spreads so easily and rapidly that it would overwhelm Earth in no time. Imagine how it would bring medical researchers together from around the planet to develop a vaccine, and in the meantime all mankind would be united, regardless of race, religion, gender or creed, to safeguard against spreading the virus for the sake of your fellow man. It would even come with a publicity campaign: 'We’re all in this together.' A motto that would appear on television and radio, on billboards and advertisements, everywhere. Every man, woman and child standing together, united against a common and deadly foe."
"Eureka! I’ve got it!" Scientist E exclaims. "What about a deadly virus that infects people indiscriminately and has no known cure. It moves through the air, and spreads so easily and rapidly that it would overwhelm Earth in no time. Imagine how it would bring medical researchers together from around the planet to develop a vaccine, and in the meantime all mankind would be united, regardless of race, religion, gender or creed, to safeguard against spreading the virus for the sake of your fellow man. It would even come with a publicity campaign: 'We’re all in this together.' A motto that would appear on television and radio, on billboards and advertisements, everywhere. Every man, woman and child standing together, united against a common and deadly foe.""How long would it take to develop this?" the Head Scientist asks, turning to Scientist F, their communicable disease expert.
"Well," Scientist F says after an uncomfortable pause, "we’ve actually been working with one in the laboratory that should be just about ready to go." He hesitates again.
"Wonderful! So, what’s the problem?"
Again there's a pause, and Scientist F clears his throat before continuing. "Well, it’s true that the virus is almost ready. It’s just that. . ."
"That what? Out with it, man!"
"Well, you see, although the virus is extremely transmissible, and it does make some people deathly ill, the survival rate overall is almost 99 percent. Most who die already have severe health problems. A lot of people only notice mild symptoms, and many who have it will never even know it."
"You’re kidding," the Chief Scientist says.
"We could warn everyone how dangerous it is," Scientist F says lamely. "That it will keep evolving, and unless they take the vaccine, once we invent it, they’re sure to die." He pauses. "It could work."
"What the hell kind of threat is that?" Scientist E shouts, rising out of his chair. "You think anybody in their right mind is going to fall for that story? They’ll laugh us right out of town! We’ll look like a bunch of fools, Chicken Littles running around telling people the sky is falling! And they’ll be right!"
"We've got to do better," the Chief Scientist says, disgustedly. "People aren’t that dumb."
Scientist F bows his head and says nothing.
Eventually, the scientists come up with a different plan, one less far-fetched: convince the nations of the world that a foreign invader threatened the planet, and that they would have to band together in order to defeat it. It would work. It had to work.
l l l
Satire, as Jonathan Swift demonstrated, can be a very effective weapon against what Hannah Arendt called "the banality of evil," to which in this case can be added, "the banality of arrogance."
What you've just read is, more or less and with a certain embellishment, the premise of "The Architects of Fear," a memorable episode of The Outer Limits first broadcast on September 30, 1963, starring Robert Culp and Geraldine Brooks.
 And the winner is—Allen Leighton!
And the winner is—Allen Leighton! In the actual story, Dr. Allen Leighton (Culp) is among the group of scientists deathly concerned about the possibility of nuclear apocalypse. The scientists have come to the conclusion that only a common enemy can unite the world and prevent a holocaust, and their answer is to create a threat from an alien planet that they are planning an invasion of earth. Rather than create fake radio transmissions or put a man in a rubber suit, they've produced an alien-type "creature" through genetic engineering that totally transforms a man's body until there is nothing human about it. The scientists agree to put their names in a hat to decide which one of them will undergo the procedure, from which there is no turning back. Allen's name, of course, is the one drawn at random, meaning that he will get to be subjected to the radical injections and surgeries necessary to transform him into the alien. Even though he is deeply in love with his wife Yvette (Brooks) and discovers that she is expecting their child (a child they both want desperately, and feared they could never have), he chooses to go ahead with it all—that's how important world peace is, and how committed he is to this plan. Yvette, of course, knows nothing of this, and will be told that her husband is dead.
l l l
At this point, let's take a step back and see where we are so far.
There is something tremendously immoral about what the scientists are up to. Fully in thrall to the "ends justify the means" school, they scheme—for that is what it is, with all its negative connotations— to employ a massive deception on the earth's population. Assuming that this works—and it's a stretch, I think—what kind of megalomania do these scientists have to have to take upon themselves the authority to engage in an act with such global consequences? Who made them God? They were not elected, they were not appointed, they simply take it upon themselves to manipulate the lives of others. It is, without doubt, a characteristic of all dictatorial, totalitarian societies. And where does it end? Having achieved world peace, do they now undertake a similar deception to end other ills? Mandatory sterilization to stop overpopulation? Deindustrialization to end air pollution? Rationing of food to cure obesity? The thing about playing God is that once you go down that road, it becomes pretty hard to pull over to the side.
 The human dimension of The Architects of Fear is heartbreaking. Forget whether or not what the scientific cabal is up to passes moral scrutiny; the anticipated sense of loss overshadowing Allen, all while he's pretending to Yvette that everything is normal, is just painful—there won't even be a chance to say goodbye. For her part, the sudden revelation of Allen's death, as she's preparing for the birth of her child, is devastating to Yvette, and to us. Anyone who's experienced that kind of loss, especially one that doesn't afford any closure—well, it results in the entire episode being permeated with an overwhelming feeling of sadness, underscored by an affecting original score from the magnificent Dominic Frontiere. It's a human dimension that science fiction doesn't often experience, so concentrated as it is on science. It's the human dimension that our scientific cabal totally overlooks; they're so intent on saving all of humanity, they forget the wonder of the individuals that make up the leviathan. In a sense, they can't see the trees for the forest.
The human dimension of The Architects of Fear is heartbreaking. Forget whether or not what the scientific cabal is up to passes moral scrutiny; the anticipated sense of loss overshadowing Allen, all while he's pretending to Yvette that everything is normal, is just painful—there won't even be a chance to say goodbye. For her part, the sudden revelation of Allen's death, as she's preparing for the birth of her child, is devastating to Yvette, and to us. Anyone who's experienced that kind of loss, especially one that doesn't afford any closure—well, it results in the entire episode being permeated with an overwhelming feeling of sadness, underscored by an affecting original score from the magnificent Dominic Frontiere. It's a human dimension that science fiction doesn't often experience, so concentrated as it is on science. It's the human dimension that our scientific cabal totally overlooks; they're so intent on saving all of humanity, they forget the wonder of the individuals that make up the leviathan. In a sense, they can't see the trees for the forest.l l l
In a 1990 study of scientists in science fiction, Patrick Parrinder writes that "Not only do scientists in science fiction often appear as lurid, melodramatic and evil, but they frequently … evoke the pre-scientific past. That is, the evil scientist—or the future scientist surviving into a post-industrial society—carries with him the trappings of sorcery, wizardry, and alchemy."
l l l
If you'll pardon the pun, it doesn't take a rocket scientist to figure out that this is destined to go horribly wrong. The transformation of Allen into the alien creature is complete (though not without some nasty reactions), and he is launched into space, to follow a reentry path that will suggest an interstellar voyage, given credibility by an announcement that an alien spacecraft is approaching earth.
 Ecce homo?However, it turns out those scientists weren't so smart after all. Due to a navigational error, Allen's ship lands not in front of the United Nations as planned, but in the woods near the laboratory, where he's set upon and shot by a frightened group of hunters. Mortally wounded, he staggers back to the lab, where he's met by Yvette, who never really believed he was dead. Allen makes a secret sign that only Yvette will recognize, and then dies, a martyr to the cause of science.
Ecce homo?However, it turns out those scientists weren't so smart after all. Due to a navigational error, Allen's ship lands not in front of the United Nations as planned, but in the woods near the laboratory, where he's set upon and shot by a frightened group of hunters. Mortally wounded, he staggers back to the lab, where he's met by Yvette, who never really believed he was dead. Allen makes a secret sign that only Yvette will recognize, and then dies, a martyr to the cause of science.It's a deceptively simple ending, and not nearly as abrupt as I'm making it out to be here. It's as tragic as the ending of any Verdi opera, and not because of the failure of the plan to bring about world peace. No, this is tragedy on a human scale, the grandest scale of all, and sets the lie to the famous line near the end of Casablanca, when Humphrey Bogart tells Ingrid Bergman that, compared to the war engulfing the world, their problems don't amount to a hill of beans. No, the tragedy of Allen and Yvette is precisely what hurts so deeply. What doth it profit the world to gain peace and lose love?
All in the name of science.
l l l
I don't know if C.S. Lewis coined the term scientism—I think he did, but in any event, he certainly provided the modern understanding of the theory, and why it was something to be feared. Lewis defined scientism as "science characterized by principles and practices tending toward controlling rather than investigating nature," resulting in what he termed a "moral devolution of science." In his book The Abolition of Man , Lewis predicted that if "scientific planning [were] cut free from traditional values" it would eventually become "joined to modern ideologies," the result of which would be
a not-so distant future in which the values and morals of the majority are controlled by a small group who rule by a perfect understanding of psychology, and who in turn, being able to see through any system of morality that might induce them to act in a certain way, are ruled only by their own unreflected whims. In surrendering rational reflection on their own motivations, the controllers will no longer be recognizably human, the controlled will be robot-like, and the Abolition of Man will have been completed.
It would be wrong to see Lewis as anti-science, though: As James A. Herrick points out in The Magician's Twin: C.S. Lewis on Science, Scientism, and Society, "Lewis respected scientific work that pursued knowledge of the natural world. Science, for Lewis, was a means of seeing and thus of appreciating nature, and the inviolability of nature was the principal value guiding its investigations. By contrast, the new science, or scientism, developed out of an impulse to see through nature by deconstructing its processes until everything in it—including the human being—was explained as a matter of mere physical causality. Scientism’s ultimate goal is placing all of nature under human control."
l l l
As a series, The Outer Limits was always skeptical of science, especially when it was put in the hands of powerful men. "The Architects of Fear" is no exception, for these powerful men, these scientists who thought they could bring the peoples of the world together, were not only trying to create fear; they were acting out of fear themselves. The episode's closing narration:
Scarecrows and magic and other fatal fears do not bring people closer together. There is no magic substitute for soft caring and hard work, for self-respect and mutual love. If we can learn this from the mistake these frightened men made, then their mistake will not have been merely grotesque. It will have been at least a lesson—a lesson at last to be learned.
We have, in our own lifetimes, seen the triumph of scientism, not just in the way we live our lives, but in the terms by which the battle is defined: the words that can be used, the concepts that can be discussed, the opinions that can be held in public. And, as is always the case, to be on the other side is to be not just different but wrong. As Christopher O. Blum points out in the article " C.S. Lewis and the Religion of Science ," "It is alarming to learn how the rise and growth of a scientific culture has been linked with the most blatant subjectivism." Now, of course, everything is subjective, thanks to scientism.
 And if that subjectivism continues, where does it end? Perhaps Scientist F's flawed virus will not be the last thing to come from that lab. We've already seen vaccines mandated, economies crushed, police states established, and lives destroyed. And then, what? Social credit expanding, healthcare and food rationed, jobs and insurance dependent on whether or not you toe the party line? Life and death itself? And by then, will any of us be recognizably human?
And if that subjectivism continues, where does it end? Perhaps Scientist F's flawed virus will not be the last thing to come from that lab. We've already seen vaccines mandated, economies crushed, police states established, and lives destroyed. And then, what? Social credit expanding, healthcare and food rationed, jobs and insurance dependent on whether or not you toe the party line? Life and death itself? And by then, will any of us be recognizably human?There is, of course, one more lesson to take from all this, one that we would all do well to remember: Except the Lord keep the city, the watchmen waketh but in vain.
And the Architects of Fear will continue to live in the night, and thrive. TV
OTHER ENTRIES IN THIS SERIES: 1984 Darkness at Noon Dialogues of the Carmelites The Obsolete Man Murder in the Cathedral Number 12 Looks Just Like You The Children's Story. . . but not just for children Moloch A Taste of Armageddon
Published on March 23, 2022 05:00
The Decent into Hell: "The Architects of Fear" (1963)

 The time: the early 1960s.
The time: the early 1960s.The place: a secret conference room in a secret underground laboratory somewhere in the world.
The audience: a dozen of the world’s top scientists.
As we look in, Scientist A is addressing the group:
"And, gentlemen, I’m pleased to announce that, with another week or two of testing, we will have turned science fiction into fact with the production model flying car!"
A hearty round of applause follows.
Scientist B then stands up. "I believe I may have done my learned colleague one better," he begins. Inserting his hand in his pocket he withdraws a small, metallic-looking rectangle slightly bigger than a credit card. "In a matter of months we will introduce a miniature telephone that not only fits in the pocket, but allows the person calling and the person being called to see each other live and in color!"
A confused murmur runs through the room. "Why would anyone want that?" one of the scientists says, as others nod their agreement.
An important-looking man (for they are all men) sitting at the head of the table interrupts the conversation. "Fellow scientists, if I may have your attention! We have something far more important to consider here than flying cars and miniature telephones. It is nothing less than the survival of mankind. Gentlemen, I am talking about world peace."
The room falls silent.
"We stand here today on the precipice of thermonuclear war. Never before have men had the ability to destroy life as we know it with such ease. Our leaders have proven themselves too impetuous, too ideologically rigid, to be trusted with such power. The average citizen is too occupied with his own problems to do anything about it. Therefore, my colleagues, the duty falls to us. It is up to us, and us alone, to save the world from itself."
There are murmurs of agreement all around.
"I have spoken with several of you over the past weeks," the Head Scientist continues, "and I believe we have hit upon the broad outline of an idea. It is our job today to turn that idea into reality, to come up with a plan that will bring all men together as one to ensure peace and harmony for all."
"But how?" Scientist C asks, on behalf of all the men in the room.
"We must concoct a threat that is so grave, so unthinkable, so overpowering in its ability to terrify, that it will unite all humanity against this perceived, common threat."
"Brilliant!" Scientist D shouts. The rest share their agreement, and the men set about discussing what such a threat would look like.
 "Eureka! I’ve got it!" Scientist E exclaims. "What about a deadly virus that infects people indiscriminately and has no known cure. It moves through the air, and spreads so easily and rapidly that it would overwhelm Earth in no time. Imagine how it would bring medical researchers together from around the planet to develop a vaccine, and in the meantime all mankind would be united, regardless of race, religion, gender or creed, to safeguard against spreading the virus for the sake of your fellow man. It would even come with a publicity campaign: 'We’re all in this together.' A motto that would appear on television and radio, on billboards and advertisements, everywhere. Every man, woman and child standing together, united against a common and deadly foe."
"Eureka! I’ve got it!" Scientist E exclaims. "What about a deadly virus that infects people indiscriminately and has no known cure. It moves through the air, and spreads so easily and rapidly that it would overwhelm Earth in no time. Imagine how it would bring medical researchers together from around the planet to develop a vaccine, and in the meantime all mankind would be united, regardless of race, religion, gender or creed, to safeguard against spreading the virus for the sake of your fellow man. It would even come with a publicity campaign: 'We’re all in this together.' A motto that would appear on television and radio, on billboards and advertisements, everywhere. Every man, woman and child standing together, united against a common and deadly foe.""How long would it take to develop this?" the Head Scientist asks, turning to Scientist F, their communicable disease expert.
"Well," Scientist F says after an uncomfortable pause, "we’ve actually been working with one in the laboratory that should be just about ready to go." He hesitates again.
"Wonderful! So, what’s the problem?"
Again there's a pause, and Scientist F clears his throat before continuing. "Well, it’s true that the virus is almost ready. It’s just that. . ."
"That what? Out with it, man!"
"Well, you see, although the virus is extremely transmissible, and it does make some people deathly ill, the survival rate overall is almost 99 percent. Most who die already have severe health problems. A lot of people only notice mild symptoms, and many who have it will never even know it."
"You’re kidding," the Chief Scientist says.
"We could warn everyone how dangerous it is," Scientist F says lamely. "That it will keep evolving, and unless they take the vaccine, once we invent it, they’re sure to die." He pauses. "It could work."
"What the hell kind of threat is that?" Scientist E shouts, rising out of his chair. "You think anybody in their right mind is going to fall for that story? They’ll laugh us right out of town. We’ll look like a bunch of fools, Chicken Littles running around telling people the sky is falling. And they’ll be right."
"We've got to do better," the Chief Scientist says, disgustedly. "People aren’t that dumb."
Scientist F bows his head and says nothing.
Eventually, the scientists come up with a different plan, one less far-fetched: convince the nations of the world that a foreign invader threatened the planet, and that they would have to band together in order to defeat it. It would work. It had to work.
l l l
Satire, as Jonathan Swift demonstrated, can be a very effective weapon against what Hannah Arendt called "the banality of evil," to which in this case can be added, "the banality of arrogance."
What you've just read is, more or less and with a certain embellishment, the premise of "The Architects of Fear," a memorable episode of The Outer Limits first broadcast on September 30, 1963, starring Robert Culp and Geraldine Brooks.
 And the winner is—Allen Leighton!
And the winner is—Allen Leighton! In the actual story, Dr. Allen Leighton (Culp) is among the group of scientists deathly concerned about the possibility of nuclear apocalypse. The scientists have come to the conclusion that only a common enemy can unite the world and prevent a holocaust, and their answer is to create a threat from an alien planet that they are planning an invasion of earth. Rather than create fake radio transmissions or put a man in a rubber suit, they've produced an alien-type "creature" through genetic engineering that totally transforms a man's body until there is nothing human about it. The scientists agree to put their names in a hat to decide which one of them will undergo the procedure, from which there is no turning back. Allen's name, of course, is the one drawn at random, meaning that he will get to be subjected to the radical injections and surgeries necessary to transform him into the alien. Even though he is deeply in love with his wife Yvette (Brooks) and discovers that she is expecting their child (a child they both want desperately, and feared they could never have), he chooses to go ahead with it all—that's how important world peace is, and how committed he is to this plan. She, of course, knows nothing of this, and will be told that her husband is dead.
l l l
At this point, let's take a step back and see where we are so far.
There is something tremendously immoral about what the scientists are up to. Fully in thrall to the "ends justify the means" school, they scheme—for that is what it is, with all its negative connotations— to employ a massive deception on the earth's population. Assuming that this works—and it's a stretch, I think—what kind of megalomania do these scientists have to have to take upon themselves the authority to engage in an act with such global consequences. Who appointed them God? They were not elected, they were not appointed, they simply take it upon themselves to manipulate the lives of others. It is, without doubt, a characteristic of all dictatorial, totalitarian societies. And where does it end? Having achieved world peace, do they now undertake a similar deception to end other ills? Mandatory sterilization to stop overpopulation? Deindustrialization to end air pollution? Rationing of food to cure obesity? The thing about playing God is that once you go down that road, it becomes pretty hard to pull over to the side.
 The human dimension of The Architects of Fear is heartbreaking. Forget whether or not what the scientific cabal is up to; the anticipated sense of loss within Leighton, all while pretending to Yvette that everything is normal, is just painful—there won't even be a chance to say goodbye. For her part, the sudden revelation of Allen's death, as she's preparing for the birth of her child, is devastating to Yvette. Anyone who's experienced that kind of loss, especially one that doesn't afford any closure—well, it results in the entire episode being permeated with an overwhelming feeling of sadness, underscored by an original score from the magnificent Dominic Frontiere. It's a human dimension that science fiction doesn't often experience, so concentrated as it is on science. It's the human dimension that our scientific cabal totally overlooks; they're so intent on saving all of humanity, they forget the wonder of the individuals that make up the leviathan. In a sense, they can't see the trees for the forest.
The human dimension of The Architects of Fear is heartbreaking. Forget whether or not what the scientific cabal is up to; the anticipated sense of loss within Leighton, all while pretending to Yvette that everything is normal, is just painful—there won't even be a chance to say goodbye. For her part, the sudden revelation of Allen's death, as she's preparing for the birth of her child, is devastating to Yvette. Anyone who's experienced that kind of loss, especially one that doesn't afford any closure—well, it results in the entire episode being permeated with an overwhelming feeling of sadness, underscored by an original score from the magnificent Dominic Frontiere. It's a human dimension that science fiction doesn't often experience, so concentrated as it is on science. It's the human dimension that our scientific cabal totally overlooks; they're so intent on saving all of humanity, they forget the wonder of the individuals that make up the leviathan. In a sense, they can't see the trees for the forest.l l l
In a 1990 study of scientists in science fiction, Patrick Parrinder writes that "Not only do scientists in science fiction often appear as lurid, melodramatic and evil, but they frequently … evoke the pre-scientific past. That is, the evil scientist—or the future scientist surviving into a post-industrial society—carries with him the trappings of sorcery, wizardry, and alchemy."
l l l
If you'll pardon the pun, it doesn't take a rocket scientist to figure out that this is destined to go horribly wrong. The transformation of Allen into the alien creature is complete (though not without some nasty reactions), and he is launched into space, to follow a reentry path that will suggest an interstellar voyage, given credibility by an announcement that an alien spacecraft is approaching earth.
 Ecce homo?However, it turns out those scientists weren't so smart after all. Due to a navigational error, Allen's ship lands not in front of the United Nations, but in the woods near the laboratory, where he's set upon and shot by a group of hunters. Mortally wounded, he staggers back to the lab, where he's met by Yvette, who never really believed he was dead. Allen makes a secret sign that only Yvette will recognize, and then dies, a martyr to the cause of science.
Ecce homo?However, it turns out those scientists weren't so smart after all. Due to a navigational error, Allen's ship lands not in front of the United Nations, but in the woods near the laboratory, where he's set upon and shot by a group of hunters. Mortally wounded, he staggers back to the lab, where he's met by Yvette, who never really believed he was dead. Allen makes a secret sign that only Yvette will recognize, and then dies, a martyr to the cause of science.It's a deceptively simple ending, and not nearly as abrupt as I'm making it out to be here. It's as tragic as the ending of any Verdi opera, and not because of the failure of the plan to bring about world peace. No, this is tragedy on a human scale, the grandest scale of all, and sets the lie to the famous line near the end of Casablanca, when Humphrey Bogart tells Ingrid Bergman that, compared to the World War, their problems don't “amount to a hill of beans.” No, the tragedy of Allen and Yvette is precisely what hurts so deeply. What doth it profit the world to gain peace and lose love?
All in the name of science.
l l l
I don't know if C.S. Lewis coined the term scientism—I think he did, but in any event, he certainly provided the modern understanding of the theory, and why it was something to be feared. Lewis defined scientism as "science characterized by principles and practices tending toward controlling rather than investigating nature," resulting in what he termed a "moral devolution of science." In his book The Abolition of Man , Lewis predicted that if "scientific planning [were] cut free from traditional values" it would eventually become "joined to modern ideologies," the result of which would be
a not-so distant future in which the values and morals of the majority are controlled by a small group who rule by a perfect understanding of psychology, and who in turn, being able to see through any system of morality that might induce them to act in a certain way, are ruled only by their own unreflected whims. In surrendering rational reflection on their own motivations, the controllers will no longer be recognizably human, the controlled will be robot-like, and the Abolition of Man will have been completed.
It would be wrong to see Lewis as anti-science, though: As James A. Herrick points out in The Magician's Twin: C.S. Lewis on Science, Scientism, and Society, "Lewis respected scientific work that pursued knowledge of the natural world. Science, for Lewis, was a means of seeing and thus of appreciating nature, and the inviolability of nature was the principal value guiding its investigations. By contrast, the new science, or scientism, developed out of an impulse to see through nature by deconstructing its processes until everything in it—including the human being—was explained as a matter of mere physical causality. Scientism’s ultimate goal is placing all of nature under human control."
l l l
As a series, The Outer Limits was always skeptical of science, especially when it was put in the hands of powerful men. "The Architects of Fear" is no exception, for these powerful men, these scientists who thought they could bring the peoples of the world together, were not only trying to create fear; they were acting out of fear themselves. The episode's closing narration
Scarecrows and magic and other fatal fears do not bring people closer together. There is no magic substitute for soft caring and hard work, for self-respect and mutual love. If we can learn this from the mistake these frightened men made, then their mistake will not have been merely grotesque. It will have been at least a lesson—a lesson at last to be learned.
We have, in our own lifetimes, seen the triumph of scientism, not just in the way we live our lives, but in the terms by which the battle is defined: the words that can be used, the concepts that can be discussed, the opinions that can be held in public. And, as is always the case, to be on the other side is to be not just different but wrong. As Christopher O. Blum points out in the article " C.S. Lewis and the Religion of Science ," "It is alarming to learn how the rise and growth of a scientific culture has been linked with the most blatant subjectivism." Now, of course, everything is subjective, thanks to scientism.
 And if that subjectivism continues, where does it end? Perhaps Scientist F's flawed virus will not be the last thing to come from that lab. We've already seen vaccines mandated, economies crushed, police states established, and lives destroyed. And then, what? Social credit expanding, healthcare and food rationed, jobs and insurance dependent on whether or not you toe the party line? Life and death itself. And then, will any of us be recognizably human?
And if that subjectivism continues, where does it end? Perhaps Scientist F's flawed virus will not be the last thing to come from that lab. We've already seen vaccines mandated, economies crushed, police states established, and lives destroyed. And then, what? Social credit expanding, healthcare and food rationed, jobs and insurance dependent on whether or not you toe the party line? Life and death itself. And then, will any of us be recognizably human?There is, of course, one more lesson to take from all this, one that we would all do well to remember: Except the Lord keep the city, the watchmen waketh but in vain.
And the Architects of Fear will continue to live in the night. TV
OTHER ENTRIES IN THIS SERIES: 1984 Darkness at Noon Dialogues of the Carmelites The Obsolete Man Murder in the Cathedral Number 12 Looks Just Like You The Children's Story. . . but not just for children Moloch A Taste of Armageddon
Published on March 23, 2022 05:00
March 21, 2022
What's on TV? Thursday, March 26, 1959

 Xhis is about as representative a week of television as you're likely to find, and there's nothing wrong with that. We know, for example, that not all shows during the Golden Age were really golden, and quite a few were even below average. Likewise, some of the shows that we're tempted to reject as naïve are actually far more accurate to the tenor of the times than we know. So as you look through these listings from the North Texas edition, concentrate on the genres, the formats, the stars, and ask yourself what they tell you about the era of the late 1960s and the early 1960s. What was considered important back then, what was still a shadow of the past, and what was a preview of things to come?
Xhis is about as representative a week of television as you're likely to find, and there's nothing wrong with that. We know, for example, that not all shows during the Golden Age were really golden, and quite a few were even below average. Likewise, some of the shows that we're tempted to reject as naïve are actually far more accurate to the tenor of the times than we know. So as you look through these listings from the North Texas edition, concentrate on the genres, the formats, the stars, and ask yourself what they tell you about the era of the late 1960s and the early 1960s. What was considered important back then, what was still a shadow of the past, and what was a preview of things to come?-4- KRLD (CBS) MORNING 7:30 CARTOONS—Kids 8:00 NEWS—Harry Reasoner 8:15 CAPT. KANGAROO—Kids Guest: Bennye Gatteys 8:45 NEWS 9:00 MORNING PLAYHOUSE “No Trial by Jury” 9:30 ARTHUR GODFREY—Variety 10:00 I LOVE LUCY—Comedy 10:30 TOP DOLLAR—Quiz 11:00 LOVE OF LIFE—Serial 11:30 SEARCH FOR TOMORROW 11:45 GUIDING LIGHT—Serial AFTERNOON 12:00 NEWS 12:15 NEWS 12:30 AS THE WORLD TURNS—Serial 1:00 JIMMY DEAN—Variety 1:30 HOUSE PARTY—Linkletter 2:00 BIG PAYOFF—Quiz 2:30 VERDICT IS YOURS—Drama 3:00 BRIGHTER DAY—Serial 3:15 SECRET STORM—Serial 3:30 EDGE OF NIGHT—Serial 4:00 MOVIE—Western “Frontier Badmen” (1943) 5:15 PARTY TIME—Tiny Grant EVENING 6:00 NEWS, WEATHER 6:15 NEWS—Douglas Edwards 6:30 I LOVE LUCY—Comedy 7:00 DECEMBER BRIDE—Comedy 7:30 SEA HUNT—Adventure 8:00 ZANE GREY—Western “Trouble at Tres Cruces” 8:30 PLAYHOUSE 90—Drama “A Trip to Paradise” 10:00 NEWS 10:15 WEATHER 10:20 PEOPLE AND PLACES—Hogan 10:30 MOVIE—Drama “Cadets on Parade” (1942)
-5- WBAP (NBC) MORNING 7:00 TODAY—Dave Garroway 9:00 DOUGH RE MI—Quiz 9:30 TREASURE HUNT—Quiz 10:00 PRICE IS RIGHT—Contest 10:30 CONCENTRATION—Contest 11:00 TIC TAC DOUGH—Quiz 11:30 IT COULD BE YOU—Leyden AFTERNOON 12:00 NEWS 12:30 PEOPLE’S CHOICE—Comedy 1:00 TRUTH OR CONSEQUENCES—Quiz COLOR 1:30 HAGGIS BAGGIS COLOR 2:00 YOUNG DR. MALONE—Serial 2:30 FROM THESE ROOTS—Serial 3:00 QUEEN FOR A DAY—Bailey 3:30 COUNTY FAIR—Bert Parks 4:00 MOVIE—Drama “The Man Who Found Himself” (1937) 5:30 TEEN-AGE DOWNBEAT COLOR EVENING 6:00 NEWS, WEATHER COLOR 6:15 NEWS—Chet Huntley 6:30 JEFFERSON DRUM—Western 7:00 STEVE CANYON—Adventure 7:30 HAYES AND HENDERSON DEBUT “A Nice Place to Hide” 8:00 BEHIND CLOSED DOORS 8:30 ERNIE FORD—Variety COLOR Guest: Lloyd Nolan 9:00 GROUCHO MARX—Quiz 9:30 MASQUERADE PARTY—Panel COLOR 10:00 NEWS 10:15 WEATHER 10:25 NEWS—Charles Murphy 10:30 SPORTS 10:35 JACK PAAR—Variety
6 KCEN (Temple) (NBC) MORNING 7:00 TODAY—Dave Garroway 9:00 DOUGH RE MI—Quiz 9:30 TREASURE HUNT—Quiz 10:00 PRICE IS RIGHT—Contest 10:30 CONCENTRATION—Contest 11:00 TIC TAC DOUGH—Quiz 11:30 IT COULD BE YOU—Leyden AFTERNOON 12:00 WEATHER—Eddie Schuster 12:05 FARM REPORT—Clark Bolt 12:25 NEWS—Eddie Schuster 12:30 MR. AND MRS. NORTH—Mystery 1:00 TRUTH OR CONSEQUENCES—Quiz COLOR 1:30 HAGGIS BAGGIS COLOR 2:00 YOUNG DR. MALONE—Serial 2:30 FROM THESE ROOTS—Serial 3:00 QUEEN FOR A DAY—Bailey 3:30 COUNTY FAIR—Bert Parks 4:00 OUR MISS BROOKS—Comedy 4:30 HAPPY HOUR—Kids 4:45 LAUREL AND HARDY—Comedy 5:00 POPEYE—Cartoon 5:30 HUCKLEBERRY HOUND EVENING 6:00 NEWS, WEATHER 6:10 SPORTS—Eddie Schuster 6:15 NEWS—Chet Huntley 6:30 JEFFERSON DRUM—Western 7:00 STEVE CANYON—Adventure 7:30 HAYES AND HENDERSON DEBUT “A Nice Place to Hide” 8:00 BEHIND CLOSED DOORS 8:30 ERNIE FORD—Variety COLOR Guest: Lloyd Nolan 9:00 GROUCHO MARX—Quiz 9:30 MASQUERADE PARTY—Panel COLOR 10:00 WEATHER, NEWS, SPORTS 10:30 JACK PAAR—Variety
-8- WFAA (ABC) MORNING 7:30 FOR KIDS ONLY—Puppets 8:30 ROMPER ROOM—Kids 9:30 TOPPER—Comedy 10:00 SUSIE—Comedy 10:30 BURNS AND ALLEN—Comedy 11:00 JULIE BENELL—Cooking 11:30 PETER LIND HAYES—Variety AFTERNOON 12:30 PLAY YOUR HUNCH—Contest 1:00 LIBERACE—Variety 1:30 OUR MISS BROOKS—Comedy 2:00 DAY IN COURT—Drama 2:30 MUSIC BINGO—Quiz 3:00 BEAT THE CLOCK—Bud Collyer 3:30 WHO DO YOU TRUST?—Quiz 4:00 AMERICAN BANDSTAND 5:30 ADVENTURE TIME—Disney EVENING 6:00 NEWS, WEATHER 6:20 SPORTS—Wes Wise 6:30 LEAVE IT TO BEAVER—Comedy 7:00 ZORRO—Adventure 7:30 REAL McCOYS—Comedy 8:00 PAT BOONE—Variety Guest: Tab Hunter 8:30 ROUGH RIDERS—Western 9:00 MIKE HAMMER—Mystery 9:30 U.S. MARSHAL—Police 10:00 NEWS 10:10 WEATHER—Dale Milford 10:15 NEWS—John Daly 10:30 MOVIE—Drama “The River” (1951)
10 KWTX (Waco) (CBS, ABC) MORNING 8:00 NEWS—Harry Reasoner 8:15 CAPT. KANGAROO—Kids Guest: Bennye Gatteys 9:00 MORNING PLAYHOUSE “No Trial by Jury” 9:30 ARTHUR GODFREY—Variety 10:00 I LOVE LUCY—Comedy 10:30 TOP DOLLAR—Quiz 11:00 BETTER LIVING—Russell 11:30 SEARCH FOR TOMORROW 11:45 GUIDING LIGHT—Serial AFTERNOON 12:00 NEWS—Walter Cronkite 12:05 NEWS—Russ Grovener 12:15 FARM REPORT—Johnny Watkins 1:00 JIMMY DEAN—Variety 1:30 HOUSE PARTY—Linkletter 2:00 BIG PAYOFF—Quiz 2:30 VERDICT IS YOURS—Drama 3:00 BRIGHTER DAY—Serial 3:15 SECRET STORM—Serial 3:30 EDGE OF NIGHT—Serial 4:00 AMERICAN BANDSTAND 5:30 ADVENTURE TIME—Disney EVENING 6:00 NEWS, WEATHER 6:15 NEWS—Douglas Edwards 6:30 OZZIE AND HARRIET—Comedy 7:00 DECEMBER BRIDE—Comedy 7:30 YANCY DERRINGER—Adventure 8:00 ZANE GREY—Western “Trouble at Tres Cruces” 8:30 PLAYHOUSE 90—Drama “A Trip to Paradise” 10:00 NEWS 10:15 WEATHER 10:20 SPORTS—Ben Vaughn 10:30 TV THEATER—Drama
11 KFJZ (Independent) MORNING 9:00 LITTLE RASCALS—Comedy 9:45 MOVIE—Double Feature 1. “Carolina Blues” (1944) 2. “Riders of the Purple Sage” (1941) 11:55 TAKE FIVE—Mark Stevens AFTERNOON 12:00 CARTOON CLUBHOUSE—Kids 12:45 MOVIE—Police “Cry of the City” (1948) 2:40 TAKE FIVE—Mark Stevens 2:45 ANN ALDEN—Interview 3:00 I MARRIED JOAN—Comedy 3:30 ROY ROGERS—Western 4:00 ABBOTT AND COSTELLO 4:30 EARLY SHOW—Kids 5:30 POPEYE—Cartoons EVENING 6:00 HUCKLEBERRY HOUND 6:30 THREE STOOGES—Comedy “Wee Wee Monsieur” 7:00 OUR GANG—Comedy “Going to Press” 7:15 MOVIE—Western “Dakota Lil” (1949) 9:00 OFFICIAL DETECTIVE—Sloane 9:30 SILENT SERVICE—Drama 10:00 MOVIE—Police “Night Court” (1932) 11:00 MOVIE—Comedy “Sailor’s Lady” (1940)
TV
Published on March 21, 2022 05:00
March 19, 2022
This week in TV Guide: March 21, 1959

 One of the items that has remained consistent in TV Guide throughout the '50s and '60s is the question of television's effect on children. As you recall, a couple of weeks ago we read an article that suggested television might have a positive role in encouraging children to read. Weighing in on the topic this week is anthropologist Margaret Mead, who ponders the effect of television violence on children.
One of the items that has remained consistent in TV Guide throughout the '50s and '60s is the question of television's effect on children. As you recall, a couple of weeks ago we read an article that suggested television might have a positive role in encouraging children to read. Weighing in on the topic this week is anthropologist Margaret Mead, who ponders the effect of television violence on children.*Another example of how inconceivable it is that today's TV Guide would have an article by someone of her stature.
Mead raises good points from the very beginning of the article—that not all violence is the same, that the very radio programs now being lauded as alternatives to violent TV were themselves condemned not that long ago as being violent—before drawing some clear differences between "good" and "bad" violence. Take fairy tales, for example. Children already have developed within them some idea of good and evil, of the weak and the strong. "Children even feel better, more like good children, their anger and hate drained safely out of them, after watching stories in which the weak encounter, battle and defeat the strong." "[T]hose who would denature fairy tales," she adds, "[taking] the chase, the shooting and the victory out of Westerns are actually constructing a world with escape without catharsis, without safe fantasy for childish aggression."
 We last heard from Dr. Mead
We last heard from Dr. Meadhere.However, she cautions, this remains true "only when the story on the screen is palpably fiction, fantasy and unreal." Even if they're angry with their parents, even if they see them (in the form of grownups in general) taken down in a television story, they still know that "they cannot do without them, even for a night." Introduce a situation in which "someone who might really be themselves now or in the future, actually kills real human beings who might be their parents or their teachers or their older brothers and sisters [and this] is quite a different matter." She also worries about the effect of such violence on the lonely child, or the child influenced by a too-real depiction of violence that has no guidelines, that doesn't say to the viewer "This is fiction, this isn't and couldn't really be you."
Part of the answer is parental supervision and involvement with what their children watch, in which they can "interject a running commentary, in which the words 'story,' 'just a story,' 'not real' are introduced, and so they can provide what the television program should itself provide." What they need to be protected from are stories in which children are either the victims or the perpetrators of violence. With the lonely child, loneliness can turn into hatred, and the violent show becomes "an incentive and program for possible crime." It seems as if many of these comments—parental involvement, not leaving children alone—are still with us today.
Mead's conclusion is that television has a unique responsibility to protect small children from "the horror and violence of real crime." If it can meet this responsibility, it will continue to provide the exciting stories that children need to experience, and "voluntarily refuse to tempt children's minds over the brink of crime."
l l l
 Starting in 1954, Steve Allen helmed his own NBC variety show which, at the beginning, aired opposite that of Ed Sullivan. It didn't run as long as Ed's, of course, but then Allen said his goal was never to conquer Ed, just to coexist with him, which he did for several seasons. Let's see who gets the best of the contest this week.
Starting in 1954, Steve Allen helmed his own NBC variety show which, at the beginning, aired opposite that of Ed Sullivan. It didn't run as long as Ed's, of course, but then Allen said his goal was never to conquer Ed, just to coexist with him, which he did for several seasons. Let's see who gets the best of the contest this week.
Sullivan: Ed's guests in this show from Portugal are Maurice Chevalier, Jacquelyn McKeever, the Ames Brothers, Richard Hearne and John Gilpin, and Marilyn Burr.
Allen: Steve's no longer a regular on Sunday, but this 90-minute special features Sammy Davis Jr., actor Sessue Hayakawa, singer Joanne Gilbert and impressionist Frank Gorshin.
Ed's in Portugal for the Carnival, and his acts have an appropriate European flair; Richard Hearne, who according to the always-reliable Wikipedia was "the first performer to be known as a 'television star' and also the first to have his own television series, is famous for playing the bumbling character Mr. Pastry on stage and television in Britain; while Maurice Chevalier needs no introduction (I think; I keep forgetting I'm probably older than most of you). Meanwhile, this Steve Allen special features a guest lineup that's just as special; Sesse Hayakawa was a major star in the silent era, and nabbed a Supporting Actor Oscar nomination as Colonel Saito in The Bridge on the River Kwai. And what do you bet Sammy Davis Jr. and Frank Gorshin exchange impressions? This is no impression, though; this week Steve takes the prize.
l l l
 It's Holy Week this week, and perhaps the week's most interesting program is also a television first—the first-ever repeat on the Hallmark Hall of Fame (Monday, 8:30 p.m., NBC). It's Marc Connelly's play "The Green Pastures," the story of a Sunday-school teacher presenting her class with stories from the Bible, based on Roark Bradford's collection of stories, Ol' Man Adam an' His Chillun. The play, which received the Pulitzer Prize for Drama in 1930, had made history on Broadway with the first all-black cast, and had then been made into a movie in 1936. Its initial live Hall of Fame presentation had been in October, 1957, where it won great acclaim but relatively few viewers, having been broadcast opposite Mike Todd's Madison Square Garden party to celebrate the first anniversary of his movie Around the World in 80 Days.*
It's Holy Week this week, and perhaps the week's most interesting program is also a television first—the first-ever repeat on the Hallmark Hall of Fame (Monday, 8:30 p.m., NBC). It's Marc Connelly's play "The Green Pastures," the story of a Sunday-school teacher presenting her class with stories from the Bible, based on Roark Bradford's collection of stories, Ol' Man Adam an' His Chillun. The play, which received the Pulitzer Prize for Drama in 1930, had made history on Broadway with the first all-black cast, and had then been made into a movie in 1936. Its initial live Hall of Fame presentation had been in October, 1957, where it won great acclaim but relatively few viewers, having been broadcast opposite Mike Todd's Madison Square Garden party to celebrate the first anniversary of his movie Around the World in 80 Days.**Walter Cronkite, who was "conscripted" into hosting what has been called "one of television's most memorably vulgar events," recalls that memorable night here.
The broadcast won a Peabody award in 1958, and Mildred Freed Alberg, executive producer of Hall of Fame, feels that this Easter week is an appropriate time to offer it again. For Monday's live broadcast, virtually the entire cast from the 1957 staging is back, including William Warfield as De Lawd and Eddie "Rochester" Anderson as Noah (a role he also played in the 1936 movie). Unfortunately, you probably wouldn't see this on TV today, or perhaps anywhere else; even in 1930 it received some criticism for its racial stereotyping, not to mention that both the play and the book on which it was based were written by white men, so it's likely unthinkable that it would be permitted today. And then there's the whole religious thing, of course. You can find the 1936 movie, but surprisingly, you can also see the second half of the 1959 broadcast here .
Earlier on Monday evening, Voice of Firestone (8:00 p.m., ABC) features Fred Waring and his Pennsylvanians with their own program of Easter music, hosted by John Daly. And on Good Friday afternoon (1:30 p.m.), NBC presents a special half-hour program featuring two rural French churches conducting the Holy Week liturgy as revised by Pope Pius XII. At the same time on ABC, Loyola (Chicago) professor Francis L. Filas, an expert on and believer in the Shroud of Turin, presents a half-hour documentary on the history of the Shroud of Turin. It's the sixth consecutive year for the show's broadcast.
l l l
By the way, before I forget:
 Be sure to get your party platters today!
Be sure to get your party platters today!l l l
Looking at the TV Teletype, we see some previews of coming attractions for the new season, with a very good record of success.
For example, an upcoming 77 Sunset Strip will serve as the pilot for a proposed detective series called Bourbon Street Beat, which does indeed premiere that fall, with Richard Long, Andrew Duggan, Van Williams and Arlene Howe. It lasts just the one season. More successful is James Michener's Adventures in Paradise, which runs for three seasons with Gardner McKay at the helm. There's also a pilot being prepared for ABC, Lincoln Jones, starring James Whitmore. This one has to wait a year, premiering in 1960 as The Law and Mr. Jones, and runs for two seasons.
From the New York Bureau, Robert Stahl reports that Vic Damone wants to be a Western star on TV, making him television's first adult singing cowboy. Watch out, Gene Autry. Stahl also mentions that, for the fifth consecutive year, NBC has won the contract to broadcast college football this fall. The payment: a cool $2,200,000. For comparison, the three major networks (ABC/ESPN, Fox and CBS; NBC has a separate contract with Notre Dame) paid a total of $1.4 billion to broadcast college football last season.
l l l
 Speaking of children and violence, guess who's back: the Three Stooges! I know, it's kind of hard to figure; for me, the Stooges have been a part of pop culture my entire life, but this was not always the case; "for years," the unbylined article says, the Stooges "were in almost total eclipse." Now, however, Screen Gems has released 78* of their old shorts into syndication, and the results can be seen in the numbers: "In Chicago their rating jumped 16 points in three months. In Philadelphia last month they had a 27.8 American Research Bureau rating, in Detroit a 14.8. Latest New York rating is 17.9." They've also made the rounds of shows like Masquerade Party and The Steve Allen Show. "This is rather rough on mothers, but the kids are happy."
Speaking of children and violence, guess who's back: the Three Stooges! I know, it's kind of hard to figure; for me, the Stooges have been a part of pop culture my entire life, but this was not always the case; "for years," the unbylined article says, the Stooges "were in almost total eclipse." Now, however, Screen Gems has released 78* of their old shorts into syndication, and the results can be seen in the numbers: "In Chicago their rating jumped 16 points in three months. In Philadelphia last month they had a 27.8 American Research Bureau rating, in Detroit a 14.8. Latest New York rating is 17.9." They've also made the rounds of shows like Masquerade Party and The Steve Allen Show. "This is rather rough on mothers, but the kids are happy."*In Television Diary, Dwight Whitney reports that Screen Gems is releasing 40 more, and have been "swamped with offers from toy manufacturers, comic-book publishers and record companies, all wishing to cut themselves in."
The current, and final, lineup of the Stooges includes Joe De Rita as the third Stooge, joining Moe Howard and Larry Fine. They're enjoying their renewed fame, especially since they weren't always such fan favorites. "The kids used to hiss me in the streets," remarks Moe, known then as the "Mean Stooge." "The other day when we finished our act, a little girl came up and kissed me. That wouldn't have happened in the old days." Adds Larry, "The kids paint our faces on eggs and electric light bulbs now. They used to throw things at us."
Moe perfectly describes their comedy as "sound" comedy. "When I belted Curley with a mallet, you heard a clear, bell-like sound. And when Larry runs a comb through his hair, you hear a crackling sound, like someone had exposed a live wire." Watch a clip of the Stooges performing live sometime; without the sound effects they're still funny, but not nearly as funny. But with 200 total Stooge shorts that continue to play on TV today, we're no longer in any danger of the Three Stooges going into eclipse again. And in these tough times, that's good news.
l l l
We'll take some quick looks at the rest of the week:
Saturday afternoon is the championship game of basketball's National Invitation Tournament, from Madison Square Garden in New York (3:00 p.m., CBS). It's won by St. John's, 76-71 over Bradley, but the curiosity is that the NIT has a national television contract—and the NCAA tournament does not. In fact, it will be well into the '60s before the Final Four becomes a television staple, while the NIT will remain a viable and popular tournament for a number of years more.
At 4:00 p.m. on Sunday, NBC presents one of those "cultural" programs I wrote about last week. It's Kaleidoscope, hosted by Chet Huntley, and this week's episode is "The Big Ear," a look at the increasing use of wiretaps and other eavesdropping equipment by law-enforcement agencies, "raising serious moral and legal issues," and asking the question, "is our classic concept of privacy being undermined by these activities?" Kind of prescient today, don't you think?
On Monday, WFAA, the ABC affiliate in Dallas-Fort Worth, presents a couple of series that have been relabeled in syndication: the newspaper drama Deadline for Action, formerly known as Wire Service, starring Dane Clark (8:30 p.m.), and Ten-Four, which, as you can probably guess, is better-known as Highway Patrol, with Broderick Crawford (9:30 p.m.). They're taking the place of the network's offerings, This is Music and The Patti Page Oldsmobile Show.
Perry Como's latest special (Tuesday, 7:00 p.m., NBC) comes to us from Broadway, where his guests are all currently starring on the Great White Way: Claudette Colbert ("The Marriage-go-round"), Gertrude Berg and Sir Cedric Hardwicke ("A Majority of One"), Cyril Ritchard ("The Pleasure of His Company"), France Nuyen ("The World of Suzie Wong"), and Juanita Hall ("Flower Drum Song").
 Wednesday gives us a variety of choices on a variety of networks: Vera Miles guests on Wagon Train (6:30 p.m., NBC), Roddy McDowell and Victor Jory are the stars of "Night of Betrayal" on The United States Steel Hour (9:00 p.m., CBS), and the Golden Gloves amateur boxing finals, live from Chicago (9:00 p.m., ABC).
Wednesday gives us a variety of choices on a variety of networks: Vera Miles guests on Wagon Train (6:30 p.m., NBC), Roddy McDowell and Victor Jory are the stars of "Night of Betrayal" on The United States Steel Hour (9:00 p.m., CBS), and the Golden Gloves amateur boxing finals, live from Chicago (9:00 p.m., ABC).On Thursday, it's the premiere of Oldsmobile Music Theater (7:30 p.m., NBC), presenting an original 30-minute story accompanied by favorite songs of the era. It seems like a lot to cram into a half-hour, but I suppose you have to see it for yourself. Tonight, it's "A Nice Place to Hide," starring Jackie Cooper and the singer Genevieve, making her TV dramatic debut. It's hosted by Bill Hayes and Florence Henderson.
Finally, on Friday, Audrey Meadows substitutes for Edward R. Murrow on Person to Person (9:30 p.m., CBS), with this week's interviewees: playwright and director Joshua Logan, and sports columnist Jimmy Cannon.
l l l
One sign of the changing times is that colleges are now offering classes for students seeking careers in television. To date, about 30% of colleges and universities offer majors in TV, but grads have yet to gain traction in the industry. "Many network and advertising-agency executives are graduates of Ivy League schools, few of which offered extensive training in television."
According to this article, though, that may be about to change. At Penn, the Annenberg School of Communications* is about to offer television courses as part of its curriculum. And there's more; New York University is offering a noncredit workshop for students to stage "a typical day in TV," while Northwestern has a six-week symposium on color TV, and the University of Denver's BA in Television includes classes in stage lighting, creative writing, production and direction, and camera work.
* Not coincidentally, Walter Annenberg is the owner of TV Guide.
For those looking to make a move into television, Professor Garnet Garrison, director of broadcasting at Michigan, has these tips when looking for a school. First, make sure the school is strong in liberal arts, as television requires a broad cultural background. Take courses in fields that will help you in television, such as psychology, literature and the arts, sociology, journalism, marketing and advertising. Look for\6ed with the school. Ask if the instructors have had meaningful experience in television. And finally, does the school itself have access to facilities that are comparable to those at television stations.
I don't know how this compares to today's education. I know that growing up, Brown Institute in Minneapolis was a renowned broadcasting school—one that I seriously considered attending myself. A look at their wall of fame shows a lot of people who went on to successful careers in local and national television. But if I had gone there, would I be writing this for you today? Who knows; maybe one of you out there would be writing about me.
l l l
 Finally, you'll recall that I once wrote about Bob Hope being "largely forgotten," although he was an enormous star in his time. This week, the cover story is on another largely forgotten TV star: Ann Sothern.
Finally, you'll recall that I once wrote about Bob Hope being "largely forgotten," although he was an enormous star in his time. This week, the cover story is on another largely forgotten TV star: Ann Sothern.Though she was never a mega-star, Ann Sothern had a more than successful career, starring in two series (Private Secretary and The Ann Sothern Show) which combined ran for eight seasons and earned her three Emmy nominations. She also played the voice of the car in My Mother the Car, which would have been reason enough to love her (for retaining her dignity, if nothing else), and was a frequent guest on shows throughout the '50s and '60s.
At this point in time, Sothern is president of five corporations, spanning everything from television production to sewing to music cataloging, and she continues to juggle these successful businesses with her own acting career. It's a tough job, and leaves her with little time for anything approaching a social life. Says Sothern, "I would like to live elegantly. Instead, I have to run five businesses."
Her last television role was in 1985; her final movie role in 1987. She has two stars on Hollywood's Walk of Fame, one for each medium. If that's the kind of career that winds up largely forgotten, I don't think I'd mind being lost to the mists of time myself. TV
Published on March 19, 2022 05:00
March 18, 2022
Around the dial

 We'll lead with the biggest story of the week, which is my final appearance on Eventually Supertrain, as Dan and I wrap up
the underappreciated Search
. There's more cool stuff on this episode, including Kolchak and the original Battlestar Galactica, and hopefully I'll be invited back one of these days! But in the meantime. . .
We'll lead with the biggest story of the week, which is my final appearance on Eventually Supertrain, as Dan and I wrap up
the underappreciated Search
. There's more cool stuff on this episode, including Kolchak and the original Battlestar Galactica, and hopefully I'll be invited back one of these days! But in the meantime. . .The Broadcasting Archives has a nice piece on one of my favorite newsmen, the great Howard K. Smith . He and Harry Reasoner were the preferred newscasters in the household when I had a chance to choose. Back then you had to be a real journalist to anchor the evening news; I wonder what he would think of the evening news today?
You would think that a television show about a crime-fighting go-go dancer would be a no-brainer, rather than a candidate for Cult TV Blog's orphaned episodes series, but as John points out, Go Girl didn't even make it to the tube. Better read and find out more.
At The Horn Section, Hal takes a look back at the 1970 made-for-TV movie Hunters Are for Killing , with a pretty good cast that includes Burt Reynolds, Melvyn Douglas, Martin Balsam, Suzanne Pleshette, Jill Banner, and Larry Storch. Hal calls it "an agreeable enough time-waster," and sometimes that's all you need.
Last week I linked to Terence's obituary of Tim Considine, and this week at Comfort TV, David takes a look at Considine's rich body of work with Disney (the real Disney, not the faux one we see nowadays): the Mickey Mouse Club serials Spin and Marty and Annette.
Speaking of Terence, over at A Shroud of Thoughts, he has a very nice appreciation of Emilio Delgado , who, of course, played Luis on Sesame Street for so many years. He died last week, aged 81, and you might be surprised to see the many roles he played on television.
At CBR, Cassidy Stephenson comments on the increasing trend of rebooting classic shows, including ten that have recently gotten a reboot . I'm not necessarily opposed to the practice, especially when you can bring back a good number of the original cast, but still—is there such a poverty of ideas out there?
Ciera Couto also notices the trend, and at The Medium she points out how rebooting contemporary children's shows like Arthur allow that generation to "[Say] hello to adulthood without saying goodbye to childhood." Here, and I always thought that's what happened when you started to pay income taxes. TV
Published on March 18, 2022 05:00
March 16, 2022
A wilted rose by any other name is still Hell
 Fernando Blanco Farias
Fernando Blanco Farias First, let me explain.
First, let me explain.I don’t actually watch The Bachelor (or The Bachelorette), and I’m pretty sure I'm not going to start—sure in that “Even with the possibility of nuclear war looming, I’m pretty sure the sun will rise tomorrow” sense of the word.
This isn't the first time I've written about the show , though. I write about it because sometimes I get bored; and when I get bored, I read; and when I read I often go to sites that I like and writers that I enjoy, and read about things that I ordinarily might not have any interest in, just because. And so that’s a long way of going about explaining how I've been happening to read Rodger Sherman’s Bachelor episode reviews in The Ringer.
 ABCWriting about this is also a good way of segueing from last week’s column about being a stranger in a strange land, because after reading about the people who populate the world of The Bachelor, I realize that I’d feel more extinct in that environment than the dodo bird would in ours. More than that, in fact, because the dodo actually existed in the real world at one time, whereas I’m pretty confident that no normal person has ever existed in the ecosystem of The Bachelor.
ABCWriting about this is also a good way of segueing from last week’s column about being a stranger in a strange land, because after reading about the people who populate the world of The Bachelor, I realize that I’d feel more extinct in that environment than the dodo bird would in ours. More than that, in fact, because the dodo actually existed in the real world at one time, whereas I’m pretty confident that no normal person has ever existed in the ecosystem of The Bachelor.Anyway, catching up on the lead-in to this season's thrilling finale, it's apparent that, even for the weird world of this show, this season's bachelor, Clayton, has committed a breach of protocol. Several, in fact, as we discover Clayton has told not one, not two, but three different women that he was wildly, madly in love with them. Oh, and he's also slept with two of them. (Well, I doubt there was any actual sleeping going on, but I'm still old fashioned about these things.) He made this revelation to the only woman he loved that he didn't sleep with, which may have been a tactical error on his part.
Upon hearing the news, Susie—the one whom he says he loves "the most"—rips into him and tells him she doesn't want anything to do with him if he's been sleeping around. Clayton, mature fellow that he is, doesn't apologize, doesn't backtrack, doesn't try to explain that he's made a mistake. No, he blames Susie for his problems. It's not like he was just being a male slut; "I was having feelings of love with this person, and I slept with them because I love this person so I’m gonna see how the physical connection is." And her response hurt his feelings, so he doesn't love her anymore.
It took me a while to finish that last paragraph, by the way; I had to go to the bathroom. I think you know what I mean.
Sherman sums up the whole situation thusly:
[Clayton] still shouldn’t have told three women that he loved them, especially in a way that made it seem like he was saying those things to only one person. And if he really loved Susie the most, he shouldn’t have had all that sex with everybody else. Meanwhile, Susie shouldn’t have issued a retroactive ultimatum on something she knew Clayton would likely do. She went on the 'have sex with multiple people' TV show and drew a secret line in the sand about whether it was OK to have sex with multiple people. Clayton is playing by Bachelor rules, while Susie is playing by the rules of real life. Both sets of actions are obviously flawed when you look at it through the other’s lens.
Bingo! This is not real life. Oh, it may be the way people behave, but it's not real life. It's a pretend world, one in which words don't mean things, actions don't have consequences, and nothing is more important than what's happening this very instant. This kind of world sounds kind of grotesque to me.
There's a wonderful moment which Sherman recounts, when Clayton is trying to explain to his parents how something like this could happen: how he could tell three women that he loved them, sleep with two of them and insult the other one, and then decide the woman he really loves is not one of the two who decided to stick with him even though he's clearly an idiot, but the one—Susie—who actually took a hike. When Clayton tries to explain to his mother that Susie actually does like him, because "she could’ve walked away at any moment," mom replies, "She did! She did walk out!" Did I mention that this isn't real life?
l l l
Bishop Fulton Sheen, in one of his television programs, said that there are three kinds of love, and used their Greek words to describe them, because there was no English word that could really measure the difference between them. The first is eros, or affectionate love, which I assume is what Clayton was thinking of in the case of these three ladies, since eros is where we get the word erotic. Then, there's philia, which is love for others made in the likeness of God. Brotherly love, as the name Philadelphia might indicate. The third is agape, or sacrificial, divine love of God for man. Pure love.
So, as I say, I think we can assume that when Clayton says he loves these women, he's talking about eros. There's an easy way to tell, though. Just because we have three distinct kinds of love doesn't mean that they don't overlap, though. One can love their spouse (eros), and because of that they're willing to sacrifice their lives for them (agape). One can love their country, and because of that they're willing to sacrifice their lives for their fellow countrymen (philia).
 So, we could have asked Clayton if screaming “I’M IN LOVE WITH YOU!!!” at the top of his lungs to each of these women means that, at this very moment, he's willing to lay down his life for them. And I'm not talking about dying in the act of saving one of them from being attacked; any of us might do that, even if the person for whom we're dying is a stranger. No, I'm thinking of that white-faced, dark-clothed Death that played chess with Max Von Sydow in The Seventh Seal. Would Clayton have played chess with Death, knowing that if he loses the game, he dies? No more parties, no more high-fives with his fellow bros, no more falling in love with the next pretty face—no, it's finito for you, pal! Somehow, I don't think his answer would have been in the affirmative.
So, we could have asked Clayton if screaming “I’M IN LOVE WITH YOU!!!” at the top of his lungs to each of these women means that, at this very moment, he's willing to lay down his life for them. And I'm not talking about dying in the act of saving one of them from being attacked; any of us might do that, even if the person for whom we're dying is a stranger. No, I'm thinking of that white-faced, dark-clothed Death that played chess with Max Von Sydow in The Seventh Seal. Would Clayton have played chess with Death, knowing that if he loses the game, he dies? No more parties, no more high-fives with his fellow bros, no more falling in love with the next pretty face—no, it's finito for you, pal! Somehow, I don't think his answer would have been in the affirmative.Of course, you've probably figured out by now that love has nothing to do with what Clayton's experiencing. At best, what he feels for these women is infatuation. Almost certainly, we're talking about lust. But to call it love, at this point, simply cheapens the word. That's not to say that it can't grow into love, but not in the length of time it takes between scoring with a woman and getting out of the bed. That may sound crude and cheap, but it's only because it is.
It also cheapens the meaning of being human, because it reduces us to animals, incapable of controlling our emotions. Man (and woman) may act in superficial ways, but we certainly aren't created that way, and when we fall to that level, we disgrace ourselves, and become a disgrace in the eyes of others.
Susie, the one woman with whom Clayton didn't sleep (and, SPOILER ALERT, the one he winds up choosing; so much for taking a principled stand), more or less admitted that, while sex is famously a part of The Bachelor, and while we can all pretend that it's painless fun for everyone, in real life, when it happens to you, things change.
I wonder how long this relationship lasts? It was revealed, in last night's live broadcast, that Clayton had chosen Susie (thereby breaking the heats of the two women he'd slept with who had, perhaps against their better judgment, chosen to remain in the competition for Clayton's "love"), so I suspect they're still together today, although given the world of The Bachelor, anything's possible. But will their love withstand it all? Will they make it to the altar, and if so, will their vows include anything about "for better, for worse, for richer, for poorer, in sickness or in health," vows that date back at least to the 1300s, by the way, or will it be more like, "So long screwy, see ya in St. Looie"?
 You can say what you want about television from the 1950s, that it was unrealistic, that it painted an idealistic portrait of America and of family life. But, as I've said before, it was also a recognizable portrait, one that others could understand and aspire to, even if they never made it themselves. If it wasn't the most illuminating programming, if it wasn't the most dramatic or the most educational or the most realistic, at least it followed the Hippocratic Oath: "Do no harm." Can we say the same about this? You may scoff at Norman Rockwell's America, but it's a hell of a lot better than finding yourself the subject of a Dorian Gray portrait.
You can say what you want about television from the 1950s, that it was unrealistic, that it painted an idealistic portrait of America and of family life. But, as I've said before, it was also a recognizable portrait, one that others could understand and aspire to, even if they never made it themselves. If it wasn't the most illuminating programming, if it wasn't the most dramatic or the most educational or the most realistic, at least it followed the Hippocratic Oath: "Do no harm." Can we say the same about this? You may scoff at Norman Rockwell's America, but it's a hell of a lot better than finding yourself the subject of a Dorian Gray portrait.I know, I know, this is the way things are now, and I might as well tell the kids to get off the lawn right now. But, dammit, there is something seriously wrong with this kind of lifestyle, and there is something even worse about splashing it across television where anyone can see it. Look, we know that people are influenced by what they see on the tube, or else no company would bother to advertise on it. We know that television sets trends, and we know that the more people see a particular kind of behavior on it, the more likely they are to find that behavior acceptable, even if they choose not to engage in it themselves. Well, it's not, and even if everyone else told me that it was, I'd still say that. (Mom to child: "And I suppose if everyone jumped off the Empire State Building, you would too.")
There's not much more to say, really. Except to throw another quote out there, not from The Bachelor, but from Thomas Jefferson, who famously said, "I tremble for my country when I reflect that God is just: that his justice cannot sleep forever." No, indeed it can't. He may just be dozing right now, in which case we truly have something to fear when He awakens completely." TV
Published on March 16, 2022 04:00
March 14, 2022
What's on TV? Wednesday, March 16, 1955

 Xome familiar names greet us in these listings from what's called the Mid-States Edition, comprising Iowa and Illinois, and including a pair of DuMont affiliates. For starters, Jack Paar's name jumps out, still hosting the CBS Morning Show. At the other end of the scale, Steve Allen's still on duty at Tonight. Eddie Fisher's guest on his NBC show is singer Morton Downey Sr., whose son Morton Jr. becomes a sensation some 30 years later. And Henry Morgan makes a rare acting appearance in the movie comedy So This Is New York on WREX's Million Dollar Movie. But for my money, the best program description in this issue—perhaps the best description you'll ever read in any TV Guide—comes from KCRG's Wrestling from Chicago: "Favorite grunt-and-groaners in action." I didn't realize the Playboy Channel was around in 1955.
Xome familiar names greet us in these listings from what's called the Mid-States Edition, comprising Iowa and Illinois, and including a pair of DuMont affiliates. For starters, Jack Paar's name jumps out, still hosting the CBS Morning Show. At the other end of the scale, Steve Allen's still on duty at Tonight. Eddie Fisher's guest on his NBC show is singer Morton Downey Sr., whose son Morton Jr. becomes a sensation some 30 years later. And Henry Morgan makes a rare acting appearance in the movie comedy So This Is New York on WREX's Million Dollar Movie. But for my money, the best program description in this issue—perhaps the best description you'll ever read in any TV Guide—comes from KCRG's Wrestling from Chicago: "Favorite grunt-and-groaners in action." I didn't realize the Playboy Channel was around in 1955.-2- WMT (Cedar Rapids) (CBS) MORNING 8:45 Tower Preview 9:00 Garry Moore—Variety 9:30 Janet Dean, R.N. 10:00 Arthur Godfrey Time 10:30 Strike It Rich—Quiz 11:00 Valiant Lady—Serial 11:15 Love of Life—Serial 11:30 Search for Tomorrow—Serial 11:45 Guiding Light—Serial AFTERNOON 12:00 Noon News—Bill Roberts 12:10 Weather and Markets 12:15 Road of Life—Serial 12:30 Welcome Travelers 1:00 Robert Q. Lewis COLOR 1:30 Home Fare—Ladies 2:00 Big Payoff—Quiz 2:30 Bob Crosby—Music 3:00 Brighter Day—Serial 3:15 Secret Storm—Serial 3:30 On Your Account—Quiz 4:00 TV Playschool—Kids 4:30 Corral Club—Marshal Jay 5:30 Superman—Adventure EVENING 6:00 Sports with Tait Cummins 6:15 Dateline Iowa—Bill Roberts 6:25 Weather Roundup 6:30 Doug Edwards 6:45 Leo and His Pioneers 7:00 ARTHUR GODFREY 8:00 THE MILLIONAIRE 8:30 I’VE GOT A SECRET Guest: Thelma Ritter. Panelists: Jayne Meadows, Bill Cullen, Faye Emerson, Henry Morgan. Garry Moore emcees. 9:00 BOXING Kid Galivan vs. Bobby Dykes 9:45 RED BARBER--Sports 10:00 SHERLOCK HOLMES 10:30 NEWS—Bob Johnson 10:45 WEATHER TOWER 10:50 SONG PARADE—Music 11:00 Tower Theater—Movie “Out of the Storm”
-4- WHBF (Rock Island) (CBS) MORNING 7:00 Morning Show—Jack Paar 8:25 News and Weather 8:30 Morning Show—Jack Paar 9:00 Garry Moore—Variety 9:30 Arthur Godfrey Time 10:30 Strike It Rich—Quiz 11:00 Valiant Lady—Serial 11:15 Love of Life—Serial 11:30 Search for Tomorrow—Serial 11:45 Guiding Light—Serial AFTERNOON 12:00 The Inner Flame—Serial 12:15 Farm Almanac 12:30 Welcome Travelers 1:00 Robert Q. Lewis COLOR 1:30 Linkletter’s House Party 2:00 Big Payoff—Quiz 2:30 Bob Crosby—Music 3:00 Brighter Day—Serial 3:15 Secret Storm—Serial 3:30 On Your Account—Quiz 4:00 Frankly Feminine—Ladies 4:30 Home, School and Community 5:00 Magic Carpet—Stories 5:30 The Buddies 5:45 News 5:55 Weather EVENING 6:00 You Asked for It—Requests 6:30 Doug Edwards 6:45 Perry Como—Music 7:00 ARTHUR GODFREY 8:00 THE MILLIONAIRE 8:30 I’VE GOT A SECRET Guest: Thelma Ritter. Panelists: Jayne Meadows, Bill Cullen, Faye Emerson, Henry Morgan. Garry Moore emcees. 9:00 BOXING Kid Galivan vs. Bobby Dykes 9:45 RED BARBER--Sports 10:00 I LED THREE LIVES—Drama 10:30 RAY BOLGER—Comedy 11:00 Late News and Weather
-6- WOC (Davenport) (NBC) MORNING 7:00 Today—Garroway 9:00 Ding Dong School—Kids 9:30 Way of the World—Serial 9:45 Sheilah Graham 10:00 Home—TV Magazine 11:00 Tennessee Ernie—Music 11:30 Feather Your Nest—Quiz AFTERNOON 12:00 Rural Roundup—Bill Gress 12:15 At Home—Mary Marshall 12:30 Especially for You—Ladies 1:00 Movie Matinee—Film 2:00 Greatest Gift—Serial 2:15 Golden Windows 2:30 One Man’s Family 2:45 Miss Marlowe—Serial 3:00 Hawkins Falls 3:15 First Love—Serial 3:30 Mr. Sweeney—Serial 3:45 Modern Romances 4:00 Pinky Lee—Variety 4:30 Howdy Doody 5:00 To Be Announced 5:30 Circle “6” Ranch—Cowboys EVENING 6:10 Four Star Sports—Hal Hart 6:15 Four Star News—Bill Mason 6:25 Weather Tower—Danico 6:30 Eddie Fisher—Music Guest: Morton Downey 6:45 News Caravan—Swayze 7:00 I MARRIED JOAN 7:30 MY LITTLE MARGIE 8:00 KRAFT THEATER—Drama “Jeannie” 9:00 THIS IS YOUR LIFE 9:30 ORIENT EXPRESS 10:00 WHO SAID THAT?—Panel 10:30 WEATHER—Phil Kane 10:35 NEWS AND SPORTS 10:45 SOIREE WITH SONTAG 11:00 Tonight—Steve Allen Guests: Dorothy Collins, Dave Brubeck 12:00 Coming Attractions
-7- KWWL (Waterloo) (NBC) MORNING 7:00 Today—Garroway 9:00 Ding Dong School—Kids 9:30 Film Subject 9:45 Sheilah Graham 10:00 Home—TV Magazine 11:00 Tennessee Ernie—Music 11:30 Feather Your Nest—Quiz AFTERNOON 12:00 News and Farm Picture 12:30 Movie Matinee 2:00 Greatest Gift—Serial 2:15 Golden Windows 2:30 One Man’s Family 2:45 Miss Marlowe—Serial 3:00 Hawkins Falls 3:15 School of the Air 3:30 Film Subject 3:45 Modern Romances 4:00 Pinky Lee—Variety 4:30 Howdy Doody 5:00 Early Show EVENING 6:00 News—John Bowles 6:15 Weather—Chet Behrman 6:20 Sports—John Bowles 6:30 Disneyland—Features 7:30 NORGE PLAYHOUSE 7:45 FILM SUBJECT 8:00 MEET CORLISS ARCHER 8:30 ALL STAR THEATER 9:00 THIS IS YOUR LIFE 9:30 BIG TOWN—Drama 10:00 WEATHER—Duane Hunting 10:05 NEWS—Nick George 10:20 SPORTS 10:30 FASHION FLOURISHES 10:45 LATE SHOW—Movie 11:30 Late News Capsule
-9- KCRG (Cedar Rapids) (ABC, DuM) AFTERNOON 4:00 Mother Wilson’s Kitchen 4:30 Cowboy Club—Movie 5:25 Crusader Rabbit—Cartoon 5:30 Captain Video—Space 5:45 Music Hall Varieties EVENING 6:00 Iowa Newsreel 6:15 John Daly—News 6:30 Disneyland—Features 7:30 STU ERWIN—Comedy 8:00 MASQUERADE PARTY 8:30 WHO SAID THAT? Panelists: Horace McMahon, June Lockhart, Bill Henry. John Daly moderates. 9:00 EISENHOWER NEWS CONFERENCE 9:30 TIMES SQUARE PLAYHOUSE 10:00 TOMORROW’S WEATHER 10:05 NIGHT BULLETIN AND SPORTS SCORES 10:15 FILM 10:25 WRESTLING—Chicago
13 WREX (Rockford) (CBS ABC) MORNING 10:15 Good Morning Film 10:30 Strike It Rich—Quiz 11:00 Valiant Lady—Serial 11:15 Love of Life—Serial 11:30 Search for Tomorrow—Serial 11:45 Just for You AFTERNOON 12:00 Markets and News 12:15 Road of Life—Serial 12:30 Coffee Time Playhouse 1:00 Robert Q. Lewis COLOR 1:15 “Rex” Presents 1:30 Party Line 13 2:00 Big Payoff—Quiz 2:30 Bob Crosby—Music 3:00 Pleasure Time 3:15 Secret Storm—Serial 3:30 Meditation Time 3:35 Let’s Talk It Over 3:45 Betty and Suzy 4:00 Roddy Mac Show 4:30 Stand By for Action 5:00 Trail Time—Western 5:30 Wild Bill Hickok—Western EVENING 6:00 Kukla, Fran and Ollie 6:15 Weather, Sports, News 6:30 Doug Edwards 6:45 Perry Como—Music 7:00 ARTHUR GODFREY 8:00 THE MILLIONAIRE 8:30 I’VE GOT A SECRET Guest: Thelma Ritter. Panelists: Jayne Meadows, Bill Cullen, Faye Emerson, Henry Morgan. Garry Moore emcees. 9:00 BOXING Kid Galivan vs. Bobby Dykes 9:45 RED BARBER--Sports 10:00 WEATHER 10:05 NEWS—Natl. and Internatl. 10:20 SPORTS 10:30 MILLION DOLLAR MOVIE “So This Is New York” 12:00 Late News
39 WTVO (Rockford) (NBC DuM) AFTERNOON 3:00 Hawkins Falls 3:15 First Love—Serial 3:30 Mr. Sweeney—Serial 3:45 Modern Romances 4:00 Pinky Lee—Variety 4:30 Howdy Doody 5:00 Fun Time—Children 5:30 Captain Video—Space 5:45 Dick Russell Show EVENING 6:00 Early Edition—News 6:15 Sports Hi-Lites 6:25 TV Weatherman 6:30 Eddie Fisher—Music Guest: Morton Downey 6:45 News Caravan—Swayze 7:00 I MARRIED JOAN 7:30 MY LITTLE MARGIE 8:00 SPORTS TIME—Wismer 8:15 INDUSTRY ON PARADE 8:30 HOTPOINT THEATER 9:00 THIS IS YOUR LIFE 9:30 LONE WOLF—Mystery 10:00 NIGHTCAP NEWS 10:15 TV WEATHERMAN 10:20 SPORTS REVIEW 10:30 STORIES OF THE CENTURY 11:00 Texas Rasslin’
TV
Published on March 14, 2022 17:07
March 12, 2022
This week in TV Guide: March 12, 1955

 As you know, Sunday has long been considered the graveyard of cultural programming, a time when the networks could prove their commitment to the edification of their viewing public by airing shows that appealed to our better nature. By airing such programming, the suits were able to accomplish two objectives:Satisfy the Federal Communications Commission that they were, in fact, fulfilling their obligations to serve the public interest, and thereby removing any obstacle to having their license renewed; andStick low-rated programs in a timeslot where they couldn't damage the ratings for the rest of their shows.I realize that this observation may strike you as somewhat cynical, but anyone who spends much time with the history of television learns to be that way. And this week we see that such an attitude dates all the way back to 1955, less than a decade into the history of American television.
As you know, Sunday has long been considered the graveyard of cultural programming, a time when the networks could prove their commitment to the edification of their viewing public by airing shows that appealed to our better nature. By airing such programming, the suits were able to accomplish two objectives:Satisfy the Federal Communications Commission that they were, in fact, fulfilling their obligations to serve the public interest, and thereby removing any obstacle to having their license renewed; andStick low-rated programs in a timeslot where they couldn't damage the ratings for the rest of their shows.I realize that this observation may strike you as somewhat cynical, but anyone who spends much time with the history of television learns to be that way. And this week we see that such an attitude dates all the way back to 1955, less than a decade into the history of American television.At last count, according to the unbylined article, there were fifteen—count 'em, fifteen—such shows on Sundays, covering a wide variety of "thought-provoking" shows, from Hallmark Hall of Fame to Meet the Press to Zoo Parade.* The networks say, wide-eyed and sincerely, that it's because Sunday is "family day," but we know better, don't we? As the author points out, many of these programs are aired without sponsors, Sundays being replete with unsold ad time. "So rather than permit their local affiliate stations to fill the day with old movies, the networks are using it to carry out their public service commitments."
*I told you it was a wide variety.
Not that kind of culture!An anonymous network vice president doesn't deny the claim, but adds that the networks are actually doing such shows a favor. On other days of the week, he points out, people are looking for entertainment, not culture. "By being scheduled on Sunday, these shows don't face the competition of the big, popular entertainment programs."
Not that kind of culture!An anonymous network vice president doesn't deny the claim, but adds that the networks are actually doing such shows a favor. On other days of the week, he points out, people are looking for entertainment, not culture. "By being scheduled on Sunday, these shows don't face the competition of the big, popular entertainment programs." It's not just plays (Omnibus) and operas (NBC Opera Theatre) that we're talking about; besides news programs like Meet the Press, NBC has Youth Wants to Know, which "brings students and government officials face to face"; meanwhile, CBS offers Face the Nation, You Are There and The American Week, For those of an artistic bent, ABC has the art and literature program Key to the Ages, and Dr. Frank Baxter's literature program Now and Then airs on CBS. Zoo Parade, Marlin Perkins' precursor to Wild Kingdom, is an NBC perennial, Horizons, CBS explores the world of natural history with Adventure, and ABC's medical program, actually airs on Sunday night.
Throughout the 1960s, this kind of programming remains a staple of Sundays, from G-E College Bowl to Science All-Stars to Johns Hopkins Science Review. (Science programs were a big deal during the space race.) Today, Sundays are almost exclusively dedicated to sports, infomercials, and the odd syndicated program or reality series. Things have certainly changed, but even if we didn't watch the cultural fare being offered, can we honestly say that television is better off without it?
l l l
It isn't often that we get to look at a program that would become a defining moment in television history, but here we are. It's Tuesday night's United States Steel Hour broadcast of "No Time for Sergeants" (8:30 p.m. CT, ABC), written by Ira Levin, based on the novel by Mac Hyman. And the significance lies in its star, Andy Griffith.
 Griffith is far from an unknown at this point; his comedy monologue "What it Was, Was Football" had gone to #1 just the previous year, back in the days when comedy records were big stuff, and Griffith had done the routine on Ed Sullivan's Toast of the Town show. He didn't, however, have a reputation as an actor, until he was cast as airman Will Stockdale, a bumpkin who drives his commanding officer, Sergeant King, crazy
Griffith is far from an unknown at this point; his comedy monologue "What it Was, Was Football" had gone to #1 just the previous year, back in the days when comedy records were big stuff, and Griffith had done the routine on Ed Sullivan's Toast of the Town show. He didn't, however, have a reputation as an actor, until he was cast as airman Will Stockdale, a bumpkin who drives his commanding officer, Sergeant King, crazyThe broadcast is a smash, and Griffith becomes synonymous with the role. As was frequently the case in the early days of television, the script is expanded and turned into first a Broadway play and then a big-screen movie, both of which star Griffith.* He garners a Tony nomination for the play, and by the time he does the movie version in 1958, he's coming off an unforgettable performance in A Face in the Crowd. Fast forward to 1960, when he appears in an episode of Make Room for Daddy as the sheriff of a small southern town who nabs Danny Thomas for driving through a stop sign.
*Also appearing in the Broadway and film productions: Don Knotts, starting a lifelong relationship with Griffith.
The name of Griffith's character in that episode is Andy Taylor. And you don't need Paul Harvey to know the rest of that story.
l l l
 We've read about Max Liebman's monthly Saturday night color spectaculars on NBC, and this month's is certainly spectacular enough: the musical comedy "A Connecticut Yankee" (8:00 p.m.), written by Richard Rodgers and Lorenz Hart and based on the Mark Twain story, with Eddie Albert, Janet Blair, and Gale Sherwood, and an appearance by Boris Karloff as King Arthur.
We've read about Max Liebman's monthly Saturday night color spectaculars on NBC, and this month's is certainly spectacular enough: the musical comedy "A Connecticut Yankee" (8:00 p.m.), written by Richard Rodgers and Lorenz Hart and based on the Mark Twain story, with Eddie Albert, Janet Blair, and Gale Sherwood, and an appearance by Boris Karloff as King Arthur. You may remember a few weeks ago our discussion about ice shows on TV. (After all, we have nothing better to do.) Well, we're back at it this Sunday, as Ed Sullivan takes Toast of the Town on the road to the great Chicago Stadium for a performance by the Ice Capades and its star, Donna Atwood . (7:00 p.m., CBS) Accompanying Ed is Dublin's Irish Festival Singers, Victor Borge, Teresa Brewer, juggler Rudy Horn, and child acrobats Vernon & Bumpy. Meanwhile, over at NBC, it's Sullivan's great rival, The Colgate Comedy Hour, with Abbott and Costello making their first hosting appearance of the season, welcoming guests Gordon MacRae, Debra Paget, and Bobo Olson, the world middleweight boxing champion. Not to turn this into a Sullivan vs. The Palace, but which show do you favor?
Here's something you don't often have: a soap opera changing its name without changing the cast or the premise. Portia Faces Life began (as so many soap operas did) on radio, in this case in 1940, and shuttled between CBS and NBC until 1953; the following year it made the move to television, debuting on CBS in April of 1954. Monday sees it come back from the weekend break as The Inner Flame (noon, CBS), while keeping everything else the same. It doesn't do much good; the show will go offer the air on July 1. I wonder what the motive was for the name change? Perhaps they were afraid it sounded too much like a sitcom, like My Little Margie, rather than a soap opera? When primetime comes around, don't miss the famous gossip columnist Hedda Hopper guesting on I Love Lucy (8:00 p.m., CBS)
 Tuesday's highlight comes after primetime on Tonight (11:00 p.m., NBC), as Steve Allen honors the famous photographer Edward Steichen, who curated the landmark photographic exhibition "The Family of Man" at the Museum of Modern Art in New York. (Steichen, one of the most influential photographers of the 20th Century, is, according to the always-reliable Wikipedia, credited with "transforming photography into an art form"; the great Stieglitz called him "the greatest photographer that ever lived."
Tuesday's highlight comes after primetime on Tonight (11:00 p.m., NBC), as Steve Allen honors the famous photographer Edward Steichen, who curated the landmark photographic exhibition "The Family of Man" at the Museum of Modern Art in New York. (Steichen, one of the most influential photographers of the 20th Century, is, according to the always-reliable Wikipedia, credited with "transforming photography into an art form"; the great Stieglitz called him "the greatest photographer that ever lived." Big doings on Wednesday's episode of Howdy Doody (4:30 p.m., NBC): the mysterious "Mr. Nick" turns out to be the mayor of Clarabell the Clown's hometown of Clowntown.* Behind the scenes, Lou Anderson takes over the role of Clarabell from Bob Nicholson, who is now playing Mr. Nick. (I wonder what that was all about?) Anderson is the third and final actor to play the famous mute clown; the originator of the role, as many of you will probably know, was Bob Keeshan.
*I didn't know Clarabell was from Washington, D.C., did you?
It's a rare color broadcast on CBS Thursday night, as Shower of Stars (7:30 p.m.) presents a musical version of the Broadway hit "Burlesque," starring Dan Dailey, Marilyn Maxwell, Joan Blondell, Jack Oakie and James Gleason. All that in just an hour. The second half of Shower has to contend with Dragnet (8:00 p.m., NBC), as Friday and Smith contend with an uncooperative husband whose wife has been kidnapped. My bet is that they'll talk him into letting them investigate the case—unless, of course, he knows what happened to her. . . (I've seen the episode, but I'm not telling.)
Schlitz Playhouse of Stars (Friday, 8:00 p.m., CBS) may have a similar title to Shower of Stars but quite a different kind of story; John Ireland stars as "a fast man with a gun who likes to right wrongs without troubling with legal processes" in "Ride to the West." Sounds like my kind of guy, doesn't he? Later on CBS, Ed Murrow's Person to Person (9:30 p.m.) spends the half-hour with hotel magnate Conrad Hilton and comedian Red Buttons.
l l l
 Not related
Not relatedl l l
 On the cover this week is the lovely Dinah Shore, one of television's most durable stars, a fixture on the small screen from 1951 to 1992. In 1955 she's spending 30 minutes a week on NBC, with her 15-minute program airing twice-weekly (Tuesdays and Thursdays, right before News Caravan); she's also headed out on tour with her supper club act, accompanied by husband George Montgomery and her 6½ year-old daughter Missy. You can see her at right during her successful gig at the Waldorf-Astoria in New York City.
On the cover this week is the lovely Dinah Shore, one of television's most durable stars, a fixture on the small screen from 1951 to 1992. In 1955 she's spending 30 minutes a week on NBC, with her 15-minute program airing twice-weekly (Tuesdays and Thursdays, right before News Caravan); she's also headed out on tour with her supper club act, accompanied by husband George Montgomery and her 6½ year-old daughter Missy. You can see her at right during her successful gig at the Waldorf-Astoria in New York City.In October, 1956, she'll graduate to a full-hour variety show (The Dinah Shore Chevy Show), which remains on the air until 1963. One of the more famous cultural touchstones of this time is the Chevy theme song, which Dinah would sing in every episode. ("See the U.S.A./in your Chevrolet.") Dinah wasn't the first celebrity to sing that jingle, though; it originated with Peter Lind Hayes and Mary Healy, who were hosting a show called Inside U.S.A. With Chevrolet (which is an interesting story in and of itself, perhaps for another day). By 1952, though, our girl Dinah was belting it out, as she would for another decade. If they hadn't composed that, though, they could always have used one of Dinah's own hits: "Nothing could be finer/than to drive around with Dinah/in your Chev-ro-let." Or maybe not. TV
Published on March 12, 2022 05:00
March 11, 2022
Around the dial

 Xefore we get to our regular Friday fare, some housekeeping:
Xefore we get to our regular Friday fare, some housekeeping:It's time once again for my occasionally somewhat annual call for guest writers. In the past I've had various excuses—I mean, reasons—for doing so, but this time I'm not working on a book, I'm not moving, I'm not poor, I'm just tired. Over the past almost eleven years, I've written more than 1,900 original pieces for It's About TV!, not to mention some original essays for The Electronic Mirror, and it's not as easy as it was when I was younger.
So if you have an idea for an essay, or if you'd like to do one of the Saturday TV Guide riffs (and the Monday listings), send me an email. If you've read the blog, you know the routine: anything that's related to classic television specifically, or the relationship between TV (classic or otherwise) and American culture, is welcome. I'll never monetize this site (other than to sell books), but I will welcome contributions of the writing sort.
We now return to our regularly scheduled programming, with the third of Jack's Hitchcock Project reviews of the work of Lewis Davidson at bare•bones e-zine. It's his adaptation of Larry M. Harris's story " The World's Oldest Motive ," with Henry Jones, Linda Lawson, and Robert Loggia; and directed by Harry Morgan!
At Cult TV Blog, John continues his look at orphaned TV shows with It's a Square World , Michael Bentine's off-kilter comedy show from 1960-64. Bentine was one of the original founders of The Goon Show, and Square World is about as off-the-wall as you'd expect.
Tim Considine , who was one of the original My Three Sons, as well as a star of Mickey Mouse Club serials and Disney movies (and was also a photographer and writer) died last week, aged 81. As usual, he gets a respectful writeup from Terence at A Shroud of Thoughts.
I'm a sucker for mid-century stuff, being a little past mid-century myself, and so JB's piece at The Hits Just Keep on Comin' naturally appeals to me: Dean Martin, the pop star . Deano really centers a place and time, doesn't he? (And by the way, much appreciated thanks to JB for the kind words!)
I don't single out video sites as much as I ought to—my focus is on the written word, but my great pleasure derives, of course, from television. And so I want to call to your attention the site Uncle Earl's Classic Television Channel , which has added a lot of new content—more episodes of many of your favorite shows, some mid-centuryish, and some from more recent times. It's really worth your time!
Something else that's worth your time: the latest at Ed Robertson's TV Confidential. I hope you keep track of this podcast on a regular basis, because Ed never has a bad show or a bad guest (except, perhaps for the cast in which I was a guest). Try out his interview with Chuck Harter on why The Untouchables is still riveting today . Because, you know, it is. TV
Published on March 11, 2022 05:00
It's About TV!
Insightful commentary on how classic TV shows mirrored and influenced American society, tracing the impact of iconic series on national identity, cultural change, and the challenges we face today.
- Mitchell Hadley's profile
- 5 followers



